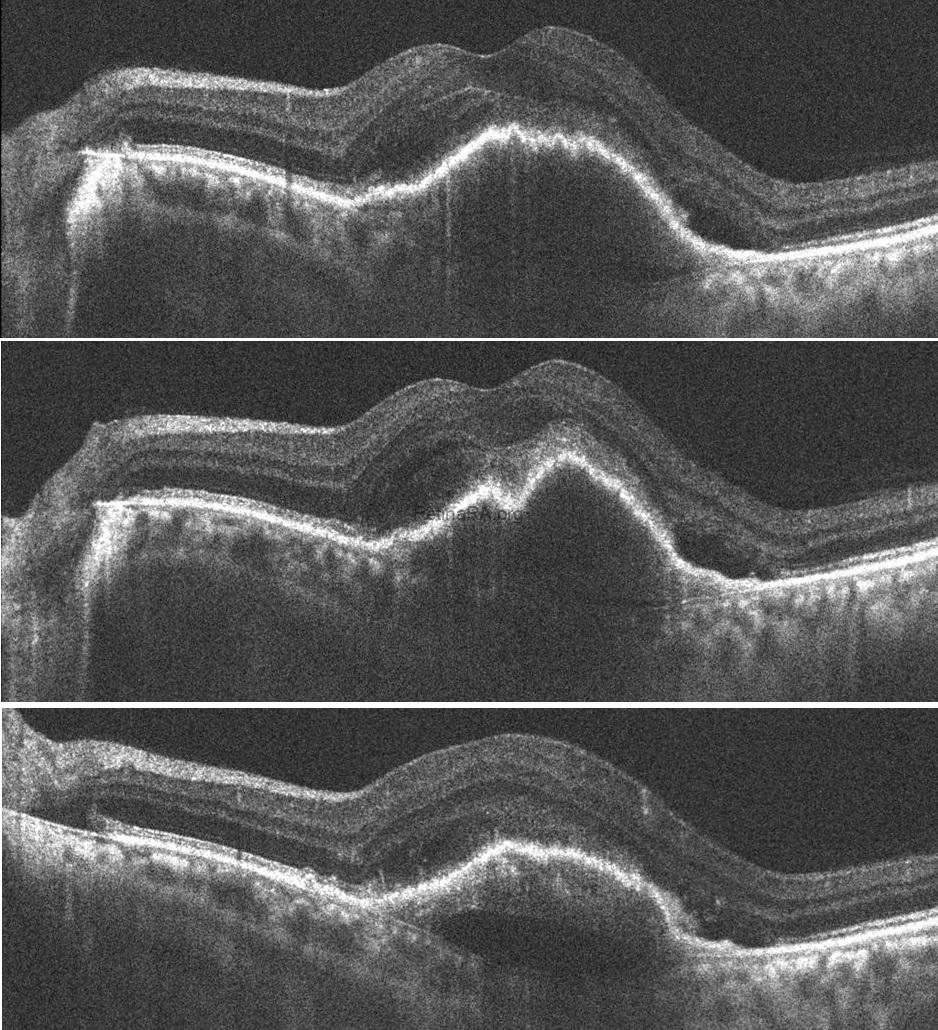
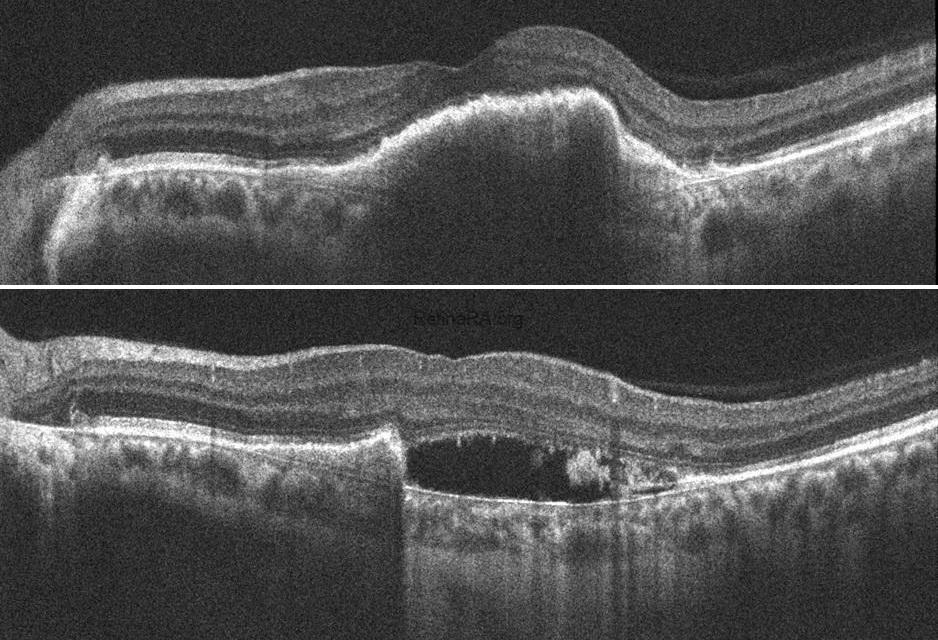

A 71-year-old man with type 1 MNV developed a retinal pigment epithelium (RPE) tear and subsequent massive submacular hemorrhage. At the first visit, his visual acuity was 20/100. There is no sign of a RPE tear on the autofluorescence image. However, OCT scans show risk factors for developing RPE tears, such as high RPE detachment (PED), corrugation of RPE , and prechoroidal cleft. Type 1 macular neovascularization (MNV), subretinal fluid, and subretinal hyperreflective material also appear on OCT.
A RPE tear developed after 1st aflibercept injection. RPE tear is breaking off the RPE of a PED on one side and folding over on itself on the opposite side. A double layer of RPE at the fovea does not cause decreased visual acuity, but if the area without RPE includes the fovea, visual acuity is severely reduced. The visual acuity of this patient improved to 20/70 because the fovea was not affected by the absence of RPE. The bare choroidal area (the area without RPE) appears red on the color photograph and distinctly hypoautofluorescent on the autofluorescent image. On the foveal horizontal OCT scan, the retracted RPE is seen as a dense hyperreflective tissue due to duplication of the RPE, and a shadowing effect beneath it. The OCT image scanning the inferior of the fovea depicts the absence of RPE. In the absence of RPE, the bare choroid area shows hyperreflectivity as a result of deeper penetration.
Aflibercept injections were continued. 2 days after 6th aflibercept injection, a massive submacular hemorrhage developed and the visual acuity of the patient decreased to hand motion. The patient underwent pneumatic subretinal hemorrhage displacement with intravitreal tPA and C3F8 gas. After pneumatic subretinal hemorrhage displacement, visual acuity increased to 20/70 again. Two months after the procedure, visual acuity was still 20/70, and the hemorrhage was completely resolved. Aflibercept injections were continued under the treat-and-extend regimen.
Credit: M. Giray Ersoz, MD, FEBO
Biruni University School of Medicine, Department of Ophthalmology, Istanbul, Turkey
Instagram accounts: @retina.review and @retina.dr.girayersoz
1st-visit imaging: Color fundus photography, autofluorescence imaging, and OCT

Imaging of RPE tear: Color fundus photography, autofluorescence imaging, and OCT

Imaging on the day submacular hemorrhage developed: Color fundus photography, autofluorescence imaging, and OCT



Imaging 2 days after pneumatic subretinal hemorrhage displacement: Color fundus photography, autofluorescence imaging, and OCT



Imaging 2 months after pneumatic subretinal hemorrhage displacement: Color fundus photography, autofluorescence imaging, and OCT





